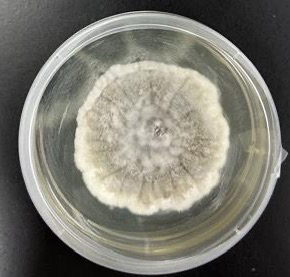

microbiology round
先日のMicrobiology roundではScedosprium属を取り上げました。
【語源】
・Sced[ばらまく]、spora[胞子]、apio[しばる]、sperma[精子]、boyd[人名].
【疫学】
・温帯地域に多く見られ、種の分布には地域差がある。(1)
・大部分は、オーストラリア、フランス、スペイン、アメリカ合衆国、インド、ドイツ、日本で報告されており、最も多く報告されている病原体はS. apiospermum。(2)
【微生物学的特徴】
・Scedosprium属には当初、Scedosporium apiospermumとS. prolificansの2種が認識されていた。その後、再分類されScedosporium属には現在18種が含まれている。
・Scedosporium属はAspergillus属に類似しており、2分枝の菌糸が見られるが、Scedosporium属ではY字型の2分枝ではなく、60-70度の角度で横に分岐することがより一般的。(3)
・標準的な真菌培地でよく増殖する。数日後、カビのコロニーは黄褐色になり、 Aspergillusとは全く異なる胞子を形成する。(3)
・Scedosporium属の形態学的特徴として、コロニーは白色や灰色、褐色の綿毛(フェルト)状の集落を形成する。菌糸幅は 2~5 μm とAspergillusの菌糸より細く、有隔壁で菌糸先端や側方には1~2個の卵円型の分生子を形成する。コロニーの発育速度や色調、性状による肉眼的な観察と、スライドカルチャー法での顕微鏡による形態から、属レベルまでは通常の細菌培養が行える施設でも同定可能である。種レベルの同定には形態学的方法に加えて質量分析法や遺伝子検査が重要となる。遺伝子検査では真菌の菌種同定で使用されるITS領域やβ-tubulin遺伝子などの塩基配列を解析することで同定可能である。(19) (20)
・βDグルカンなどの真菌マーカーに関する臨床研究は不足している。Scedosporium脳膿瘍およびL. prolificans真菌血症の症例報告では、血清βDグルカンが補助的検査として有用である可能性が示されている。(4)(5)
・通常無菌の部位からScedosporium属菌を分離すれば 診断可能。血液からScedosporium属菌を培養できるのは稀。(6)
・喀痰、気管支肺胞洗浄液、排液創、または副鼻腔吸引液からの菌の分離は、塗抹標本または生検で菌糸が認められない限り、感染の確固たる証拠とはなり得ない。(7)
【臨床像】
・2つの異なる疾患を引き起こす。
1. Mycetoma(菌腫):慢性皮膚感染症(粒状のものをつくる)
2. Scedosporiosis:Scedosporium属菌によって引き起こされる他のすべての感染症
・感染経路
(i)空気中に漂っている胞子を吸い込む、
(ii)怪我をした際に環境中の真菌が体内に入り込む(8)
・リスク因子:固形臓器移植と血液疾患の治療。(9)
・Scedosporium症の最も一般的な部位は、肺、骨、関節、および中枢神経系。副鼻腔炎、角膜炎、眼内炎、皮膚・軟部組織感染症、前立腺炎、心内膜炎も報告されている。(10)
・副鼻腔などの空気を含む空間は、胞子形成しやすい環境。好中球減少症の患者では、血管侵襲と血栓症がよく見られる。(3)
・世界中の土壌や淡水、特に溜まった水や汚染された水中に存在する。肺や副鼻腔に吸入したり、皮膚を通じた外傷によって感染が起こる。汚染された水での溺水後にScedosporium関連肺炎を発症した症例が多く報告されている。(3)
・定着は多いが、侵襲性肺アスペルギルス症に類似した侵襲性肺疾患が発生し、通常は免疫不全患者に見られる。外傷により、免疫正常者の眼、軟部組織、骨関節感染症の最も一般的な原因。CNS感染症は、免疫不全者と健康な人の両方に見られる。(11)
・免疫正常患者における感染症は通常、亜急性から慢性の経過をたどるが、免疫不全患者における感染症は頻繁に急性かつ重症。(3)
<呼吸器感染症>
・Aspergillus属に次いで2番目に頻繁に分離される真菌病原体。(12)
・侵襲性肺アスペルギルス症と同様に、侵襲性肺スセドスポリウム症は、遷延性好中球減少症の患者、長期間の高用量コルチコステロイド療法を受けている患者、または同種骨髄移植を受けた患者で最も多く発生する。(13)
・播種を伴う侵襲性肺疾患はよく見られ、後天性免疫不全症候群(AIDS)患者や固形臓器移植後にも発生している。(14) (15)
・重度の免疫不全患者における肺疾患は、通常、発熱、咳、胸膜痛、そしてしばしば喀血として現れる。胸部X線検査では、結節性陰影、肺胞浸潤、consolidation、または空洞形成が認められることがある。(16)
【治療】
・Scedosporium症の効果的な治療法は依然として分かっていない。アムホテリシンBに対するin vitroおよび臨床的耐性、ならびにブレークスルー感染が繰り返し報告されている。(17)
・複数の研究において、ボリコナゾールベースの治療の転帰は、あらゆる製剤のアムホテリシンBによる治療よりも優れていたという報告がある。(17)(18)
・外科的デブリードマンは、軟部組織、骨、関節、胸膜および副鼻腔の治療において重要な補助手段となっているが、それ単独では治癒できない。関節内へのアムホテリシンB注入が、少数の患者における治療成功に寄与した可能性がある。脳膿瘍の死亡率は75%を超えると言われている。(11)
・ボリコナゾール単剤による治療失敗も報告されており、リポソーマルアムホテリシンB、ポサコナゾールの使用、ボリコナゾールへのミカファンギンの追加による治療成功の報告もある。ガイドラインではサルベージ療法としてポサコナゾールへの変更、もしくはエキノカンジン系の追加が中等度に推奨されている。
・アゾール系およびエキノカンジン系に対するin vitro感受性はさまざまであることが報告されている。(9)
・抗真菌薬と併行して免疫抑制のレベルを下げることが極めて重要である。
【治療期間】
・Scedosporium属細菌感染症の最適な治療期間はまだ確立されていないが、感染症の徴候や症状が消失するまで治療を継続することが推奨される。
・Scedosporium属細菌感染症の大部分が、3~6 か月の追跡期間中に抗真菌治療に反応を示している。これは、少なくとも 6 か月の長期治療が必要である可能性を示唆している。(2)
(1) Kaltseis J, Rainer J, De Hoog GS. Ecology of Pseudallescheria and Scedosporium species in human-dominated and natural environments and their distribution in clinical samples. Med Mycol 2009; 47: 398–405.
(2) Scedosporiosis and lomentosporiosis: modern perspectives on these difficult-to-treat rare mold infections. Clin Microbiol Rev. 2024;37(2):e0000423.
(3) Mandell, Douglas, and Bennett's Principles and Practice of Infectious Diseases, 2-Volume Set, 10th Edition
(4) Nishimori M, Takahashi T, Suzuki E, Kodaka T, Hiramoto N, Itoh K, Tsunemine H, Yarita K, Kamei K, Takegawa H, Takahashi T. 2014. Fatal fungemia with Scedosporium prolificans a patient with acute myeloid leukemia. Med Mycol J 55:E63–70.
(5) Levesque E, Rizk F, Noorah Z, Aït-Ammar N, Cordonnier-Jourdin C, El Anbassi S, Bonnal C, Azoulay D, Merle JC, Botterel F. 2017. Detection of (1,3)-β-D-glucan for the diagnosis of invasive fungal infection in liver transplant recipients. Int J Mol Sci 18:862
(6) Cortez K.J., Roilides E., Quiroz-Telles F., et al.: Infections caused by Scedosporium spp . Clin Microbiol Rev. 2008; 21: pp. 157-197.
(7) Fernandez-Flores A., Lopez-Medrano R., Fuster-Foz C.: Histopathological clues in the diagnosis of fungal infection by Scedosporium in a case of endophthalmitis starting as conjunctivitis . J Cutan Pathol 2016; 43: pp. 461-467.
(8) Scedosporiosis and lomentosporiosis: modern perspectives on these difficult-to-treat rare mold infections. Clin Microbiol Rev. 2024;37(2):e0000423.
(9) Hoenigl M., Salmanton-Garcia J., Walsh T.J., et al.: Global guideline for the diagnosis and management of rare mould infections: an initiative of the European confederation of medical mycology in cooperation with the International Society for human and animal mycology and the American Society for Microbiology . Lancet Infect Dis 2021; 21: pp. e246-e257.
(10) Guarro J., Kantarcioglu A.S., Horre R., et al.: Scedosporium apiospermum: changing clinical spectrum of a therapy-refractory opportunist . Med Mycol 2006; 44: pp. 295-327.
Cortez K.J., Roilides E., Quiroz-Telles F., et al.: Infections caused by Scedosporium spp . Clin Microbiol Rev. 2008; 21: pp. 157-197.
(11) Kantarcioglu A.S., Guarro J., de Hoog G.S.: Central nervous system infections by members of the Pseudallescheria boydii species complex in healthy and immunocompromised hosts: epidemiology, clinical characteristics and outcome . Mycoses 2008; 51: pp. 275-290.
(12) Heath CH, Slavin MA, Sorrell TC, et al. Population-based surveillance for scedosporiosis in Australia: epidemiology, disease manifestations and emergence of Scedosporium aurantiacum infection. Clin Microbiol Infect 2009; 15: 689–93
(13) Husain S., Munoz P., Forrest G., et al.: Infections due to Scedosporium apiospermum and Scedosporium prolificans in transplant recipients: clinical characteristics and impact of antifungal agent therapy on outcome . Clin Infect Dis 2005; 40: pp. 89-99.
(14) Lamris G.A., Chamilos G., Lewis R.E., et al.: Scedosporium infection in a tertiary care cancer center: a review of 25 cases from 1989-2006 . Clin Infect Dis 2006; 43: pp. 1580-1584.
(15)Castiglioni B., Dutton D.A., Rinaldi M.G., et al.: Pseudallescheria boydii (anamorph Scedosporium apiospermum ): infection in solid organ transplant recipients in a tertiary medical center and review of the literature . Medicine (Baltimore) 2002; 81: pp. 333-348.
(16) Kantarcioglu A.S., de Hoog G.S., Guarro J.: Clinical characteristics and epidemiology of pulmonary pseudallescheriasis . Rev Iberoam Micol 2012; 29: pp. 1-13.
(17) Seidel D, Mei©¨ner A, Lackner M, et al. Prognostic factors in 264 adults with invasive Scedosporium spp and Lomentospora prolificans infection reported in the literature and FungiScope. Crit Rev Microbiol 2019; 45: 1–21
(18) Scedosporium apiospermum and Scedosporium prolificans in transplant recipients: clinical characteristics and impact of antifungal agent therapy on outcome. Clin Infect Dis 2005; 40: 89–99.
(19) 一般社団法人日本医真菌学会 希少深在性真菌症の診断・治療ガイドライン
(20) 畠山裕司, et al. Scedosporium 属が分離された津波肺の 3 症例. 日臨微誌, 2012, 22: 289-297.

このサイトの監修者
亀田総合病院
臨床検査科部長、感染症内科部長、地域感染症疫学・予防センター長 細川 直登
【専門分野】
総合内科:内科全般、感染症全般、熱のでる病気、微生物が原因になっておこる病気
感染症内科:微生物が原因となっておこる病気 渡航医学
臨床検査科:臨床検査学、臨床検査室のマネジメント
研修医教育